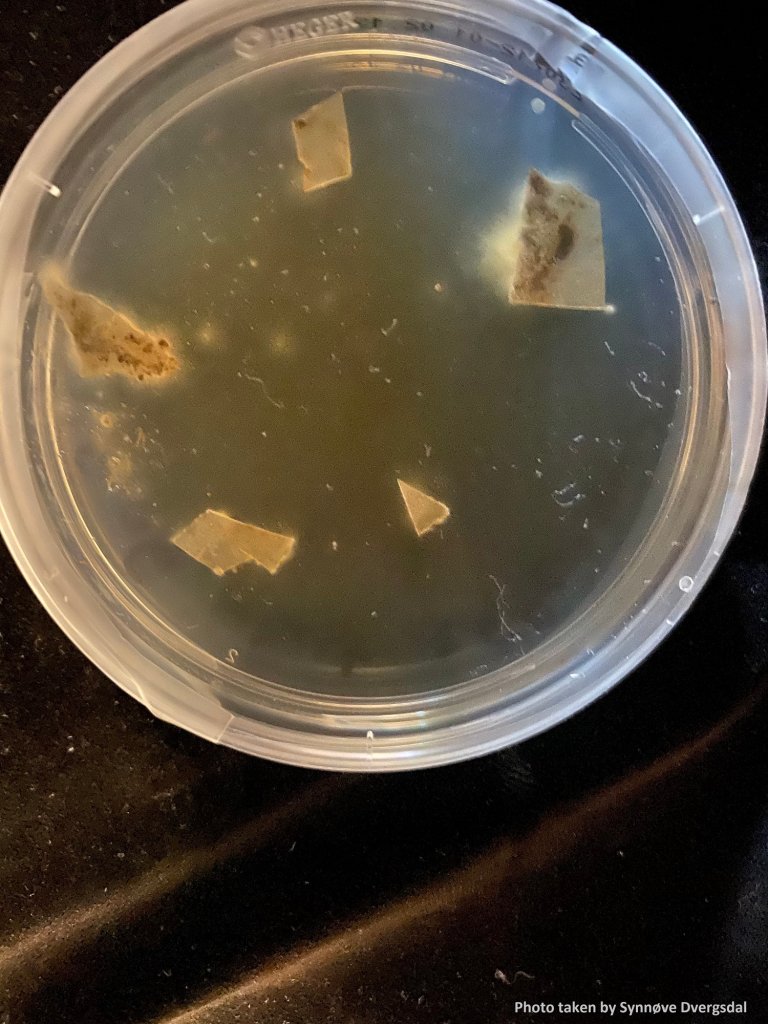
Petriskål med plastbiter og nypodede sopp. Foto: Anan Zhao

Bli en folkeforsker
Vi leter etter folkeforskere som vil bidra i prosjektet Jekyll og Hyde. Prosjektet handler om forholdet mellom plastavfall og muggsopp, nærmere bestemt om hvordan skadelige sopparter kan spres med plastavfall, og hvordan noen sopparter kan bryte ned plastavfall.
Oppdatert 16. mai 2024
Folkeforskerregistreringen er nå stengt siden vi har mottatt nok prøver til eksperimentene. Hvis du allerede er registrert kan du fortsatt sende inn prøvene frem til 31. mai.
Tusen takk for at du ville bidra!
-----------------------------------------------------------------------------------------------------------
Vi håper at dere kan hjelpe oss med å samle inn plastavfallsprøver. Prøvene du samler inn vil bli undersøkt for bakterier og muggsopp som vil bli artsbestemt ved hjelp av DNA sekvensering. Ut ifra disse dataene vil vi velge ut noen sopparter for videre forsøk der vi undersøker om disse kan hjelpe med å bryte ned plastavfall.

Du mottar en pakke med:
- Fem merkede poser for prøvetaking
- En kort instruksjon
- Et kort spørreskjema
- En konvolutt for retur av prøvene
Vi vil sende deg påminnelser om retur av prøvene.
Her finner du bruksanvisning av plastprøver og demonstrasjon.
Tusen takk for ditt bidrag!

.jpg)
.jpg)
